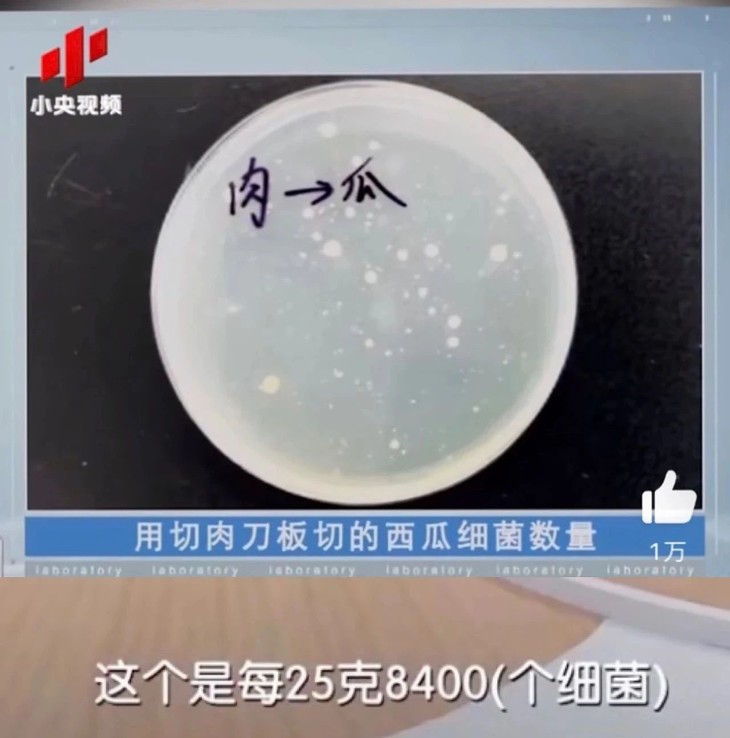

💥💥19.9元秒杀【Velosan温仑山巴利水果刀5寸】 刀口锋利,切果不留汁 自带镂空刀套,通风沥水便于收纳 0329返团
| 运费: | 免运费 |
商品详情
产品名称:Veloson温仑山巴利水果刀5寸
产品规格:银杏花 太阳花
产品材质:不锈钢(3Cr13)+PP
产品尺寸:5寸
发货地:杭州
发货快递:顺丰
发货时效:72小时内
不发货地区:新疆,西藏港澳台不发货
售后规则:支持7天无理由
🔥🔥🔥无底线的清仓又来了,
还是我们熟悉的品牌Velosan温仑山
这一批货是国外客户定制的,多备了些当备用。现在大货已发走
旗舰店89.9元不打折
💰💰本团到手仅19.9元❗❗
一杯奶茶的钱,品质超好,能用很久很久

Velosan温仑山这个品牌也不用多介绍吧
相信大家也曾被这款风靡全网的鹅卵石炒锅种草了吧
至今锅具界还流传着它的神话,是其他锅子无法取代的,
超多主播带货,单月直播破亿
他们家产品单价都不便宜
低至19.9元迄今为止就这一款,以后也不会有😘😘

VELOSAN温仑山 不锈钢水果刀🥑
🔹3Cr13不锈钢材,硬度高,耐腐蚀
🔹刀口锋利,切果不留汁
🔹自带镂空刀套,通风沥水便于收纳
我们和品牌沟通,剩下的库存就当给粉丝福利吧,感谢大家对velosan温仑山 的喜爱和支持💞💞
到手才只要19.9元😂对你没看错❗❗
品质大家放心,一如既往的好💪💪

✅✅3Cr13不锈钢材质的,可以当水果刀,辅食刀,切片刀,家用或者露营带出去都很方便哦
3Cr13不锈钢材具有良好的耐腐蚀性能,刀具坚韧耐磨,不易变形损坏
1⃣刀具持久锋利不易钝
2⃣刀刃黄金弧设计,充分模拟手掌受力,轻盈趁手,切割更省力
3⃣水果刀片不能太长,否则难以操作
也不能太短,短了不能将水果一切两半
13cm长的大片,西瓜🍉也能放心切啦
4⃣好的刀具,一个趁手好把握的手柄是必不可少的
刀把采用PP手柄,更贴合手掌,防滑更省力,久握不累
适用与多种不同场景
5⃣切果不留汁
切熟食,切水果不易破坏水果纤维
优质不锈钢材,耐腐蚀,耐生锈
6⃣Velosan温仑山的水果刀实力更有颜值,经典的印花系列,为单调的生活増彩
✅搭配镂空刀套设计,通风沥水便于收纳
























随意用菜刀切削水果是非常不卫生的,
因为菜刀常接触肉、鱼、蔬菜
🍴🍴刀上会附着寄生虫及其虫卵或其他病菌
用来切水果会污染水果
容易引起肠胃不舒服的问题
特别是对于有宝宝的家庭,小孩子的肠胃还比较脆弱
如果吃到被细菌污染的水果就很容易闹肚子
而且如果不清洗赶紧就很容易吃到辣椒味的西瓜🍉😂😂😂

试验人员将切过肉的菜刀冲洗后,用来切西瓜
经检测,这种情况下的西瓜内,每25g含有高达8400个细菌。
所以为了身体健康,专门用一把水果刀是更有必要的
velosan温仑山的水果刀就是解决这个问题的好帮手
🌿能够适应不同的使用场景,不仅能切水果还能削皮
🌿配合人体工学设计,握感舒适省力的水果刀
厨房里备上这样一把水果刀
小小的花费却能让日常的饮食更安全卫生🍎
吃到每一口都是新鲜的味道🍒🍒

- 首品生活
- 买的少一点 买的好一点 SUPER LIFE
- 扫描二维码,访问我们的微信店铺




















